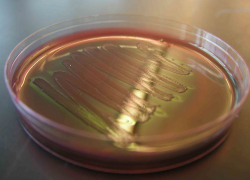
В Пятигорске нашли кишечную палочку во многих продуктах питания

Происшествия
 Парни уверяли покупателей, что продают оригинальные часы известных брендов
Студенты на Ставрополье продавали контрафактные часы через интернет
15.08.2014 06:07
Парни уверяли покупателей, что продают оригинальные часы известных брендов
Студенты на Ставрополье продавали контрафактные часы через интернет
15.08.2014 06:07
 В суде состоялось оглашение последнего слова подсудимого, теперь его ожидает приговор
Бывшему главе Михайловска 19 августа огласят приговор
15.08.2014 05:59
В суде состоялось оглашение последнего слова подсудимого, теперь его ожидает приговор
Бывшему главе Михайловска 19 августа огласят приговор
15.08.2014 05:59
 В отношении преступника завершено расследование
Житель Ставрополья убил мужчину из-за разногласий в технологиях ремонта
15.08.2014 05:11
В отношении преступника завершено расследование
Житель Ставрополья убил мужчину из-за разногласий в технологиях ремонта
15.08.2014 05:11
Пожарные на Ставрополье 10 часов тушили возгорание, начавшееся из-за поджога мусора на свалке
15.08.2014 01:18
 Мужчина обвиняется в изнасиловании и угрозе убийством
Насильнику из Новоалександровска грозит 20 лет тюрьмы
15.08.2014 01:02
Мужчина обвиняется в изнасиловании и угрозе убийством
Насильнику из Новоалександровска грозит 20 лет тюрьмы
15.08.2014 01:02
 После этого парень немедленно скрылся с места происшествия
Угонщик на Ставрополье украл авто и попал на нем в ДТП
14.08.2014 11:52
После этого парень немедленно скрылся с места происшествия
Угонщик на Ставрополье украл авто и попал на нем в ДТП
14.08.2014 11:52
 Подозреваемые потребовали взятку в 40 тыс рублей за непроведение проверок
Сотрудников налоговой службы на Ставрополье подозревают во взяточничестве
14.08.2014 09:45
Подозреваемые потребовали взятку в 40 тыс рублей за непроведение проверок
Сотрудников налоговой службы на Ставрополье подозревают во взяточничестве
14.08.2014 09:45
 Молодого человека пытались задержать за распитие спиртного в общественном месте
В Ставрополе 16-летний парень сломал полицейскому нос
14.08.2014 09:20
Молодого человека пытались задержать за распитие спиртного в общественном месте
В Ставрополе 16-летний парень сломал полицейскому нос
14.08.2014 09:20
 Молодые люди исчезли около своего дома 1,5 года назад
Два парня в Ставрополе объявлены в розыск
14.08.2014 08:37
Молодые люди исчезли около своего дома 1,5 года назад
Два парня в Ставрополе объявлены в розыск
14.08.2014 08:37
 Организации нарушали законы «Об охране окружающей среды» и «Об отходах производства и потребления»
В воздухе Пятигорска нашли опасные загрязнители
14.08.2014 04:20
Организации нарушали законы «Об охране окружающей среды» и «Об отходах производства и потребления»
В воздухе Пятигорска нашли опасные загрязнители
14.08.2014 04:20
 Беби-боксы создадут в трех городах края, где число оставленных детей наиболее высоко
На Ставрополье решили создать беби-боксы для брошенных детей
14.08.2014 02:13
Беби-боксы создадут в трех городах края, где число оставленных детей наиболее высоко
На Ставрополье решили создать беби-боксы для брошенных детей
14.08.2014 02:13
 Житель города Учкекен вступил с девочкой-подростком в интимную связь
На Ставрополье парень соблазнил 15-летнюю школьницу
14.08.2014 01:33
Житель города Учкекен вступил с девочкой-подростком в интимную связь
На Ставрополье парень соблазнил 15-летнюю школьницу
14.08.2014 01:33
 До конца рабочей недели температура будет подниматься до 40 градусов
На Ставрополье сохранится экстремальная жара
14.08.2014 01:03
До конца рабочей недели температура будет подниматься до 40 градусов
На Ставрополье сохранится экстремальная жара
14.08.2014 01:03
Жительница Ставрополя сменила имя, чтоб не платить за коммуналку
13.08.2014 11:39
 Пострадавший мужчина был доставлен в больницу с травмами
На Ставрополье сотрудница полиции сбила велосипедиста
13.08.2014 10:14
Пострадавший мужчина был доставлен в больницу с травмами
На Ставрополье сотрудница полиции сбила велосипедиста
13.08.2014 10:14
 Женщина осталась жива и получила травмы
В Пятигорске разыскивают водителя, который сбил пенсионерку и скрылся
13.08.2014 07:14
Женщина осталась жива и получила травмы
В Пятигорске разыскивают водителя, который сбил пенсионерку и скрылся
13.08.2014 07:14
 Мужчина был настолько пьян, что начал тонуть на мелководье, на глубине всего в 1,5 метра
На Новопятигорском озере спасли пьяного тонувшего мужчину
13.08.2014 04:30
Мужчина был настолько пьян, что начал тонуть на мелководье, на глубине всего в 1,5 метра
На Новопятигорском озере спасли пьяного тонувшего мужчину
13.08.2014 04:30
 Здание уже несколько лет находится в полуразрушенном состоянии
Дом с привидениями горел в Ставрополе
13.08.2014 02:43
Здание уже несколько лет находится в полуразрушенном состоянии
Дом с привидениями горел в Ставрополе
13.08.2014 02:43
 Сотрудник полиции совершил угон вместе с жителем Михайловска
Полицейский на Ставрополье подозревается в угоне автомобиля
13.08.2014 01:03
Сотрудник полиции совершил угон вместе с жителем Михайловска
Полицейский на Ставрополье подозревается в угоне автомобиля
13.08.2014 01:03
 Четыре человека из легковушки пострадали, в Газели пострадавших нет
На Ставрополье Приора столкнулась с пассажирской Газелью
12.08.2014 12:52
Четыре человека из легковушки пострадали, в Газели пострадавших нет
На Ставрополье Приора столкнулась с пассажирской Газелью
12.08.2014 12:52
 Уголовное дело направлено в суд
Депутата на Ставрополье будут судить за смерть ребенка в ДТП
12.08.2014 12:34
Уголовное дело направлено в суд
Депутата на Ставрополье будут судить за смерть ребенка в ДТП
12.08.2014 12:34
 Мужчина нанес 78-летней бабушке сильный удар по голове
Житель Ставрополья заключен под стражу за убийство старушки-инвалида
12.08.2014 10:54
Мужчина нанес 78-летней бабушке сильный удар по голове
Житель Ставрополья заключен под стражу за убийство старушки-инвалида
12.08.2014 10:54
 Сейчас по факту находки ведется доследственная проверка
На Ставрополье нашли человеческие останки предположительно времен ВОВ
12.08.2014 09:44
Сейчас по факту находки ведется доследственная проверка
На Ставрополье нашли человеческие останки предположительно времен ВОВ
12.08.2014 09:44
 Мужчина получил 7 лет лишения свободы
Жителя Ставрополя осудили в Выборге за хранение 11 кг гашиша
12.08.2014 08:58
Мужчина получил 7 лет лишения свободы
Жителя Ставрополя осудили в Выборге за хранение 11 кг гашиша
12.08.2014 08:58
 Авария произошла на улице 50 лет ВЛКСМ
15-летний пассажир пострадал в ДТП в Ставрополе
12.08.2014 04:02
Авария произошла на улице 50 лет ВЛКСМ
15-летний пассажир пострадал в ДТП в Ставрополе
12.08.2014 04:02
 Дело передано в суд
На Ставрополье завершено расследование по факту рухнувшей Карусели в парке аттракционов
11.08.2014 12:39
Дело передано в суд
На Ставрополье завершено расследование по факту рухнувшей Карусели в парке аттракционов
11.08.2014 12:39
 Мальчик умер от острой вирусной инфекции
На Ставрополье малыш скончался по вине безответственной мамы
11.08.2014 11:10
Мальчик умер от острой вирусной инфекции
На Ставрополье малыш скончался по вине безответственной мамы
11.08.2014 11:10
 Ребенок находился в квартире один, и после вдыхания газа из нескольких зажигалок, скончался
На Ставрополье погибла несовершеннолетняя девочка, вдыхавшая газ из зажигалок
11.08.2014 10:23
Ребенок находился в квартире один, и после вдыхания газа из нескольких зажигалок, скончался
На Ставрополье погибла несовершеннолетняя девочка, вдыхавшая газ из зажигалок
11.08.2014 10:23
 Несмотря на это, суд приговорил его к 4 месяцам обязательных работ
Алиментщик на Ставрополье выплатил долг сыну прямо в зале суда
11.08.2014 09:55
Несмотря на это, суд приговорил его к 4 месяцам обязательных работ
Алиментщик на Ставрополье выплатил долг сыну прямо в зале суда
11.08.2014 09:55
 Грабитель был установлен
В Ставрополе неизвестный грабитель похитил у пенсионерки 150 тыс рублей
11.08.2014 02:14
Грабитель был установлен
В Ставрополе неизвестный грабитель похитил у пенсионерки 150 тыс рублей
11.08.2014 02:14
 В результате пожара погибли три маленьких ребенка
По факту пожара в Томузловском возбудили уголовное дело
10.08.2014 03:32
В результате пожара погибли три маленьких ребенка
По факту пожара в Томузловском возбудили уголовное дело
10.08.2014 03:32
 Парни обокрали 14-летнюю девушку и попытались скрыться
Уличных грабителей на Ставрополье удалось задержать за 15 минут
09.08.2014 09:07
Парни обокрали 14-летнюю девушку и попытались скрыться
Уличных грабителей на Ставрополье удалось задержать за 15 минут
09.08.2014 09:07
 У мужчины нашли 1 пистолет и 30 видов холодного оружия
Ставропольца подозревают в незаконной торговле антикварным оружием
09.08.2014 07:59
У мужчины нашли 1 пистолет и 30 видов холодного оружия
Ставропольца подозревают в незаконной торговле антикварным оружием
09.08.2014 07:59
 Трагедия случилась в Буденновском районе
Три маленьких ребенка погибли в Ставропольском крае при пожаре
09.08.2014 04:28
Трагедия случилась в Буденновском районе
Три маленьких ребенка погибли в Ставропольском крае при пожаре
09.08.2014 04:28
 Между мужчиной и подростками произошла ссора в кафе, после чего девушек затолкнули в автомобиль и увезли в неизвестном направлении
В Ставрополе мужчина незаконно лишил свободы двух несовершеннолетних девушек
08.08.2014 10:49
Между мужчиной и подростками произошла ссора в кафе, после чего девушек затолкнули в автомобиль и увезли в неизвестном направлении
В Ставрополе мужчина незаконно лишил свободы двух несовершеннолетних девушек
08.08.2014 10:49
 Экспертиза показала, что останкам уже около 10 лет
На Ставрополье в реке Кума обнаружили человеческие скелетированные останки
07.08.2014 09:58
Экспертиза показала, что останкам уже около 10 лет
На Ставрополье в реке Кума обнаружили человеческие скелетированные останки
07.08.2014 09:58
 Когда к мальчику приехала скорая, он находился в состоянии клинической смерти
В Ставрополе 5-летнего ребенка придавило грифом от штанги
07.08.2014 09:15
Когда к мальчику приехала скорая, он находился в состоянии клинической смерти
В Ставрополе 5-летнего ребенка придавило грифом от штанги
07.08.2014 09:15
 Женщина скончалась на месте
В Ставрополе напротив ОРТЦ «Ставрополь» сбили пенсионерку
07.08.2014 04:58
Женщина скончалась на месте
В Ставрополе напротив ОРТЦ «Ставрополь» сбили пенсионерку
07.08.2014 04:58
 Мужчина долгое время уклонялся от выплаты и в итоге суд решил отобрать у него иномарку
Должник в Ставрополе рассчитался с банком иномаркой
07.08.2014 03:25
Мужчина долгое время уклонялся от выплаты и в итоге суд решил отобрать у него иномарку
Должник в Ставрополе рассчитался с банком иномаркой
07.08.2014 03:25
 Подросток получил травмы и был госпитализирован
В Ставрополе автомобиль сбил несовершеннолетнего скутериста
07.08.2014 01:12
Подросток получил травмы и был госпитализирован
В Ставрополе автомобиль сбил несовершеннолетнего скутериста
07.08.2014 01:12
 Возгорание произошло в частном доме
Трех человек спасли на пожаре в Новоселицком районе
06.08.2014 12:06
Возгорание произошло в частном доме
Трех человек спасли на пожаре в Новоселицком районе
06.08.2014 12:06
В 5 наименованиях продукта обнаружили вредоносную бактерию
В Пятигорске нашли кишечную палочку во многих продуктах питания
06.08.2014 09:10
В 5 наименованиях продукта обнаружили вредоносную бактерию
В Пятигорске нашли кишечную палочку во многих продуктах питания
06.08.2014 09:10
 Мужчины требовали от местного жителя 300 тыс рублей за отказ в возбуждении уголовного дела
Полицейских на Ставрополье задержали за взятку и наркоторговлю
06.08.2014 06:32
Мужчины требовали от местного жителя 300 тыс рублей за отказ в возбуждении уголовного дела
Полицейских на Ставрополье задержали за взятку и наркоторговлю
06.08.2014 06:32
 Мужчину отправляют в колонию за месяц до освобождения
Ярослава Белоусова, осужденного по Болотному делу, этапируют на Ставрополье
06.08.2014 05:29
Мужчину отправляют в колонию за месяц до освобождения
Ярослава Белоусова, осужденного по Болотному делу, этапируют на Ставрополье
06.08.2014 05:29
 Мужчина обналичил более 5 млн рублей
Житель Ставрополья будет осужден за незаконное обналичивание денег
06.08.2014 02:56
Мужчина обналичил более 5 млн рублей
Житель Ставрополья будет осужден за незаконное обналичивание денег
06.08.2014 02:56
 Грабители обчистили букмекерскую контору несколько дней назад, и их не могли найти
Банду грабителей задержали на Ставрополье
06.08.2014 02:42
Грабители обчистили букмекерскую контору несколько дней назад, и их не могли найти
Банду грабителей задержали на Ставрополье
06.08.2014 02:42
 В преступлении подозреваются двое жителей 18 и 20 лет
На Ставрополье двое шантажистов заставили несовершеннолетнюю вступить с ними в интимные отношения
06.08.2014 01:33
В преступлении подозреваются двое жителей 18 и 20 лет
На Ставрополье двое шантажистов заставили несовершеннолетнюю вступить с ними в интимные отношения
06.08.2014 01:33
 66-летний мужчина скончался на месте
В Пятигорске Мерседес насмерть сбил пенсионера
05.08.2014 11:56
66-летний мужчина скончался на месте
В Пятигорске Мерседес насмерть сбил пенсионера
05.08.2014 11:56
 ДТП случилось на ФАД «Кавказ»
На Ставрополье грузовик столкнулся с мотоциклом: двое погибших
05.08.2014 09:34
ДТП случилось на ФАД «Кавказ»
На Ставрополье грузовик столкнулся с мотоциклом: двое погибших
05.08.2014 09:34
 Парень выпивал со своим знакомым, а потом угнал его автомобиль со стоянки
На Ставрополье задержали нетрезвого угонщика
05.08.2014 04:45
Парень выпивал со своим знакомым, а потом угнал его автомобиль со стоянки
На Ставрополье задержали нетрезвого угонщика
05.08.2014 04:45
 Подозреваемый убил мужчину в 2001 году и с тех пор скрывался
На Ставрополье задержали убийцу, находившегося в розыске 13 лет
05.08.2014 03:50
Подозреваемый убил мужчину в 2001 году и с тех пор скрывался
На Ставрополье задержали убийцу, находившегося в розыске 13 лет
05.08.2014 03:50
 Погибших и пострадавших при пожарах нет
Около 240 пожаров произошли на Ставрополье за выходные
05.08.2014 01:09
Погибших и пострадавших при пожарах нет
Около 240 пожаров произошли на Ставрополье за выходные
05.08.2014 01:09
 Злоумышленник был задержан
На Ставрополье мошенник списал деньги с чужого банковского счета
04.08.2014 09:40
Злоумышленник был задержан
На Ставрополье мошенник списал деньги с чужого банковского счета
04.08.2014 09:40
 Мужчина копал траншею и задел ковшом кабель
Житель Ставрополя оставил более тысячи домов без света из-за незаконного рытья траншеи
04.08.2014 05:48
Мужчина копал траншею и задел ковшом кабель
Житель Ставрополя оставил более тысячи домов без света из-за незаконного рытья траншеи
04.08.2014 05:48
 У лидера группировки изъяли около 5 млн рублей
Банда фальшивомонетчиков задержана на Ставрополье
04.08.2014 04:57
У лидера группировки изъяли около 5 млн рублей
Банда фальшивомонетчиков задержана на Ставрополье
04.08.2014 04:57
В Ставрополе разыскивают свидетелей аварии с участием полицейского
04.08.2014 01:36
 Нацистскую идеологию парень пропагандировал в социальной сети \"Вконтакте\"
За пропаганду экстремизмв в интернете нациста осудили на Ставрополье
03.08.2014 09:15
Нацистскую идеологию парень пропагандировал в социальной сети \"Вконтакте\"
За пропаганду экстремизмв в интернете нациста осудили на Ставрополье
03.08.2014 09:15
 Водителя удалось задержать, полицейский доставлен в больницу с травмой головы
Пьяный водитель на Ставрополье протащил инспектора ДПС по асфальту
03.08.2014 05:20
Водителя удалось задержать, полицейский доставлен в больницу с травмой головы
Пьяный водитель на Ставрополье протащил инспектора ДПС по асфальту
03.08.2014 05:20
 В ходе массовой драки пострадал мужчина
В Ставрополе день ВДВ закончился дракой в кафе
02.08.2014 09:52
В ходе массовой драки пострадал мужчина
В Ставрополе день ВДВ закончился дракой в кафе
02.08.2014 09:52
 Мальчик попал с тяжелейшими ожогами в больницу
6-летний ребенок пострадал на Ставрополье из-за жидкости для розжига
01.08.2014 11:18
Мальчик попал с тяжелейшими ожогами в больницу
6-летний ребенок пострадал на Ставрополье из-за жидкости для розжига
01.08.2014 11:18
 Несовершеннолетнего парня вызвали вместе с мамой для проведения беседы
Героя бешеной поездки на авто удалось установить сотрудникам ГИБДД
01.08.2014 11:08
Несовершеннолетнего парня вызвали вместе с мамой для проведения беседы
Героя бешеной поездки на авто удалось установить сотрудникам ГИБДД
01.08.2014 11:08
 Подозреваемыми оказались трое жителей села Курсавка
Трое парней на Ставрополье задержаны за кражу на заправке
01.08.2014 09:09
Подозреваемыми оказались трое жителей села Курсавка
Трое парней на Ставрополье задержаны за кражу на заправке
01.08.2014 09:09
 Ребенок болел несколько недель, а его родители не обращались в больницу за помощью
В Ставропольском крае двухмесячный малыш скончался от вирусной инфекции
01.08.2014 02:37
Ребенок болел несколько недель, а его родители не обращались в больницу за помощью
В Ставропольском крае двухмесячный малыш скончался от вирусной инфекции
01.08.2014 02:37
В Ставрополе пропал без вести несовершеннолетний подросток
31.07.2014 11:30
 Несчастный случай произошел из-за драки между мужчинами
На Ставрополье осудят мужчину, из-за которого годовалый ребенок лишился глаза
31.07.2014 10:58
Несчастный случай произошел из-за драки между мужчинами
На Ставрополье осудят мужчину, из-за которого годовалый ребенок лишился глаза
31.07.2014 10:58
 Мужчина проживал вместе с отцом и не платил ему алименты
В Пятигорске суд обязал сына выплачивать отцу алименты
31.07.2014 10:24
Мужчина проживал вместе с отцом и не платил ему алименты
В Пятигорске суд обязал сына выплачивать отцу алименты
31.07.2014 10:24
В детский сад на Ставрополье заползла двухметровая ящерица
31.07.2014 10:04
 Трагедия произошла 31 июля днем на базе отдыха «Горизонт»
Ставропольский подросток утонул в Волгодонске
31.07.2014 06:47
Трагедия произошла 31 июля днем на базе отдыха «Горизонт»
Ставропольский подросток утонул в Волгодонске
31.07.2014 06:47
 Мужчины хотели денег за незаведение уголовного дела на задержанного с наркотиками
Наркополицейские вымогали взятку на Ставрополье
31.07.2014 06:03
Мужчины хотели денег за незаведение уголовного дела на задержанного с наркотиками
Наркополицейские вымогали взятку на Ставрополье
31.07.2014 06:03
 Сумма похищенного составила 120 тыс рублей
Домработница похитила у хозяйки золотые изделия
31.07.2014 04:42
Сумма похищенного составила 120 тыс рублей
Домработница похитила у хозяйки золотые изделия
31.07.2014 04:42
 Мужчина поругался со знакомым и устроил поножовщину в квартире
В Ставрополе задержали нарушителя общественного порядка
31.07.2014 01:54
Мужчина поругался со знакомым и устроил поножовщину в квартире
В Ставрополе задержали нарушителя общественного порядка
31.07.2014 01:54
 Полиция нашла преступника благодаря звонку соседей, пожаловавшихся на ночной шум
Житель Башкортостана, разыскиваемый за наркотики, задержан на Ставрополье за ночной шум
30.07.2014 10:42
Полиция нашла преступника благодаря звонку соседей, пожаловавшихся на ночной шум
Житель Башкортостана, разыскиваемый за наркотики, задержан на Ставрополье за ночной шум
30.07.2014 10:42
 Мужчин удалось задержать, сейчас они находятся под стражей
Двое молодых людей на Ставрополье ограбили букмекерскую контору
30.07.2014 08:35
Мужчин удалось задержать, сейчас они находятся под стражей
Двое молодых людей на Ставрополье ограбили букмекерскую контору
30.07.2014 08:35
 Причину смерти ребенка сейчас выясняет следственный комитет
На Ставрополье от удушья скончалась новорожденная девочка
30.07.2014 08:17
Причину смерти ребенка сейчас выясняет следственный комитет
На Ставрополье от удушья скончалась новорожденная девочка
30.07.2014 08:17
 Проверка показала, что в алкоголь добавлен ацетон
На Ставрополье изъяли более 1300 бутылок поддельного алкоголя
30.07.2014 07:04
Проверка показала, что в алкоголь добавлен ацетон
На Ставрополье изъяли более 1300 бутылок поддельного алкоголя
30.07.2014 07:04
В Ставрополе и пригороде вода будет подаваться хуже, чем раньше
30.07.2014 04:38
 Мужчина отделался очень мягким наказанием за свои действия
Мужчина на Ставрополье угодил в колонию за избиение ребенка и полицейских
30.07.2014 03:59
Мужчина отделался очень мягким наказанием за свои действия
Мужчина на Ставрополье угодил в колонию за избиение ребенка и полицейских
30.07.2014 03:59
 Мужчина неоднократно совершал действия сексуального характера в отношении сестры девушки, с которой он встречался
Бывшего сотрудника МВД будут судить за изнасилование 9-летней девочки
29.07.2014 11:23
Мужчина неоднократно совершал действия сексуального характера в отношении сестры девушки, с которой он встречался
Бывшего сотрудника МВД будут судить за изнасилование 9-летней девочки
29.07.2014 11:23
 Злоумышленник украл автомобиль прямо с парковки
В Ставрополе задержали угонщика автомобиля
29.07.2014 10:27
Злоумышленник украл автомобиль прямо с парковки
В Ставрополе задержали угонщика автомобиля
29.07.2014 10:27
 Его нашли вместе с мобильным телефоном, зажатым в руке
На Ставрополье при загадочных обстоятельствах утонул мужчина на одной из баз отдыха
29.07.2014 05:03
Его нашли вместе с мобильным телефоном, зажатым в руке
На Ставрополье при загадочных обстоятельствах утонул мужчина на одной из баз отдыха
29.07.2014 05:03
 Женщина снимала квартиру и нанимала девушек на работу
Ставропольчанку осудили за организацию занятий проституцией
29.07.2014 04:44
Женщина снимала квартиру и нанимала девушек на работу
Ставропольчанку осудили за организацию занятий проституцией
29.07.2014 04:44
 Парень оформил несколько кредитов на сумму более 2 млн рублей по фиктивным документам
На Ставрополье сотрудник банка оказался мошенником
28.07.2014 11:37
Парень оформил несколько кредитов на сумму более 2 млн рублей по фиктивным документам
На Ставрополье сотрудник банка оказался мошенником
28.07.2014 11:37
 Злоумышленнику выбрана мера пресечения - содержание под стражей
Наркоман, напавший на соседей в Ставрополе, арестован
28.07.2014 11:20
Злоумышленнику выбрана мера пресечения - содержание под стражей
Наркоман, напавший на соседей в Ставрополе, арестован
28.07.2014 11:20
 Водитель автомобиля Форд не справился с управлением и налетел на ВАЗ-2115: ВИДЕО
На Ставрополье произошла авария: двое погибли
28.07.2014 06:01
Водитель автомобиля Форд не справился с управлением и налетел на ВАЗ-2115: ВИДЕО
На Ставрополье произошла авария: двое погибли
28.07.2014 06:01
 Ребенок утонул на оросительном канале в селе Птичьем
На Ставрополье утонул 5-летний мальчик
28.07.2014 04:15
Ребенок утонул на оросительном канале в селе Птичьем
На Ставрополье утонул 5-летний мальчик
28.07.2014 04:15
 Две девочки 2-х и 9-и лет были доставлены в больницу на лечение
В ДТП в Ставрополе пострадали 2 ребенка
28.07.2014 03:35
Две девочки 2-х и 9-и лет были доставлены в больницу на лечение
В ДТП в Ставрополе пострадали 2 ребенка
28.07.2014 03:35
 Температура за последние неделе в крае не падала ниже 30 градусов
Засуха на Ставрополье угрожает урожаю подсолнечника и кукурузы
28.07.2014 03:32
Температура за последние неделе в крае не падала ниже 30 градусов
Засуха на Ставрополье угрожает урожаю подсолнечника и кукурузы
28.07.2014 03:32
В отношении полицейского, сбившего насмерть пешехода в Ставрополе, возбуждено уголовное дело
27.07.2014 10:31
 ДТП случилось на одной из улиц краевого центра
Полицейский Ставрополя подозревается в совершении смертельного ДТП
26.07.2014 11:27
ДТП случилось на одной из улиц краевого центра
Полицейский Ставрополя подозревается в совершении смертельного ДТП
26.07.2014 11:27















